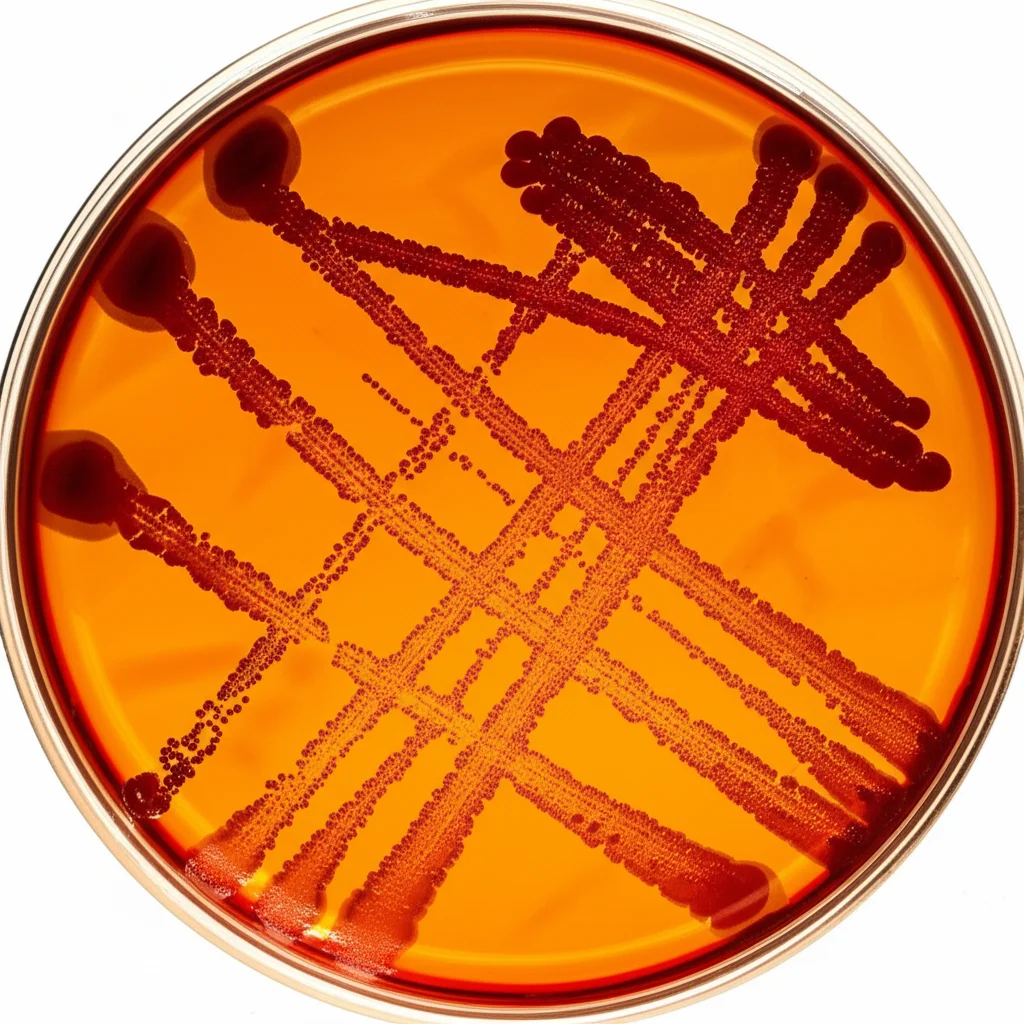
Macro fotografia, obiettivo 100mm, di diverse colonie batteriche (Streptococchi, Lattobacilli, Candida) su una piastra di agar, con illuminazione laterale per esaltare le texture e i colori distinti delle colonie, alta definizione.

Diabete e Sorrisi dei Bimbi: Cosa Nasconde la Loro Bocca?
Ciao a tutti! Oggi voglio portarvi con me in un viaggio affascinante, quasi da detective, nel microscopico mondo che si nasconde nella bocca dei nostri bambini, soprattutto quando c’è di mezzo il diabete di tipo 1. Sapete, la salute della bocca è un po’ come la spia di quello che succede nel resto del corpo, e con il diabete sembra esserci un legame a doppio filo. Ma è davvero così? E cosa c’entra con la carie? Domande che mi frullavano in testa e a cui, insieme a un team di ricercatori, abbiamo cercato di dare una risposta.
L’indagine: piccoli pazienti, grandi scoperte
Per capirci qualcosa di più, abbiamo coinvolto un gruppo di 63 bambini. Alcuni erano affetti da diabete di tipo 1, divisi tra chi aveva un buon controllo glicemico e chi, purtroppo, faticava un po’ di più a tenere a bada la glicemia. E poi, ovviamente, un gruppo di bambini sani come confronto. Cosa abbiamo fatto? Beh, abbiamo dato un’occhiata super attenta alla loro salute orale, usando strumenti specifici come il CAST (Caries Assessment Spectrum and Treatment) per valutare la carie e l’OHIS (oral hygiene index simplified) per misurare l’igiene. Ma il bello doveva ancora venire! Abbiamo raccolto campioni di saliva e di placca – sì, quella patina fastidiosa che si forma sui denti – per andare a caccia dei veri protagonisti: i microbi! In particolare, ci siamo concentrati sui famigerati Mutans Streptococchi, sui Lattobacilli e su diverse specie di Candida. L’obiettivo? Capire se ci fossero differenze nella “popolazione” microbica tra i vari gruppi e come questa si relazionasse allo stato di salute dei denti e alla gravità del diabete.
I “soliti sospetti” del cavo orale
Quando si parla di carie, alcuni nomi saltano subito all’orecchio. Gli Streptococchi mutans sono considerati i principali colpevoli, soprattutto nelle fasi iniziali della demineralizzazione dello smalto. Poi ci sono i Lattobacilli, che non danno il via alla carie ma contribuiscono alla sua progressione. E non dimentichiamoci dei funghi, come la Candida albicans, che spesso si trova in quantità maggiori nei bambini con carie. Insomma, un vero e proprio “ecosistema” complesso e, a volte, un po’ turbolento.
Nel nostro studio, gli Streptococchi mutans salivari erano presenti nell’82,5% dei campioni, i Lattobacilli salivari nel 74,6% e la Candida albicans salivare nel 58,7%. Altre specie di Candida, messe insieme, si trovavano nel 46% dei casi. Numeri che ci dicono già molto sulla “fauna” orale dei piccoli.
Diabete e carie: un legame non così scontato
E qui arriva una delle prime scoperte interessanti: nonostante si pensi spesso che il diabete aumenti il rischio di carie, nel nostro studio non abbiamo trovato una differenza statisticamente significativa nello stato di salute orale (misurato con l’indice OHIS) o nell’incidenza di carie (valutata con il punteggio CAST) tra i bambini sani e quelli diabetici, indipendentemente dal controllo glicemico. Sorprendente, vero? Questo risultato è in linea con alcuni studi precedenti, ma contrasta con altri che invece vedono i bambini diabetici più a rischio. La verità, probabilmente, è che la carie è una malattia multifattoriale, e il diabete è solo uno dei tanti tasselli del puzzle.  Forse le abitudini alimentari più controllate dei bambini diabetici, con una minore assunzione di zuccheri, o una maggiore attenzione all’igiene orale, giocano un ruolo nel bilanciare la situazione.
Forse le abitudini alimentari più controllate dei bambini diabetici, con una minore assunzione di zuccheri, o una maggiore attenzione all’igiene orale, giocano un ruolo nel bilanciare la situazione.
Ma il profilo microbico… quello sì che cambia!
Se la carie non sembrava fare distinzioni nette, il discorso cambiava parecchio quando andavamo a “contare” i microbi.
Abbiamo notato che la presenza di Streptococchi mutans salivari era significativamente più alta nei bambini con diabete non controllato rispetto ai soggetti sani. E parlando di Candida albicans salivare, questa era meno frequente nei bambini diabetici con un buon controllo glicemico. Addirittura, altre specie di Candida, come la C. dubliniensis e la C. tropicalis, si facevano vedere più spesso nella saliva dei bambini con un controllo glicemico scarso.
Un altro dato che mi ha colpito riguarda gli Streptococchi mutans nella placca: ne abbiamo trovati di più nei bambini con un’igiene orale peggiore e, di nuovo, con un controllo glicemico meno efficace. Sembra quasi che questi batteri approfittino di un ambiente “zuccherino” e di una pulizia non ottimale per proliferare.
Candida e Lattobacilli: indicatori da non sottovalutare
La Candida albicans, sia nella saliva che nella placca, sembrava fregarsene dello stato glicemico quando si trattava di carie: le sue quantità erano maggiori nei bambini con una situazione cariosa peggiore, diabetici o no. Questo suggerisce un suo ruolo attivo nel processo carioso, forse indipendente dal diabete stesso.
E i Lattobacilli salivari? Beh, loro sembrano essere dei veri e propri “indicatori” dello stato di salute dei denti. La loro conta era più alta nei soggetti con una condizione di carie peggiore. Curiosamente, i Lattobacilli salivari erano più abbondanti nei bambini sani (euglicemici) rispetto ai diabetici, mentre quelli nella placca erano più numerosi nel gruppo diabetico. Questo potrebbe indicare che l’ambiente glicemico più elevato nella placca dei diabetici favorisca la loro colonizzazione sulla superficie del dente. È un aspetto che merita sicuramente ulteriori approfondimenti, perché ci fa capire come il metabolismo di questi batteri possa essere influenzato diversamente a seconda del “distretto” orale e dello stato sistemico.
Igiene orale: un fattore sempre cruciale
Non potevamo non considerare l’igiene orale. E infatti, abbiamo visto che i bambini con un’igiene orale meno curata (OHIS ≥ 0.7) avevano quantità significativamente maggiori di Streptococchi mutans nella placca e anche di Candida albicans nella placca. Questo conferma, se mai ce ne fosse bisogno, quanto sia fondamentale spazzolare bene i denti!
Analizzando l’interazione tra igiene orale e diabete, è emerso che i bambini con diabete ben controllato mostravano le quantità più basse di Streptococchi mutans salivari, indipendentemente dal livello di igiene. Per la Candida salivare, invece, i livelli erano più alti nel gruppo con diabete controllato rispetto agli altri due gruppi, a prescindere dall’igiene. La Candida nella placca, invece, sembrava risentire sia del controllo glicemico che dell’igiene. Un bel rompicapo, eh?
Cosa ci portiamo a casa da questa ricerca?
Allora, tirando le somme di questa avventura nel microcosmo orale, cosa possiamo dire?
Innanzitutto, che il diabete di tipo 1 nei bambini, di per sé, non sembra tradursi automaticamente in un maggior rischio di carie. Tuttavia, il profilo microbiologico orale è decisamente diverso tra bambini sani e diabetici, e il livello di controllo glicemico gioca un ruolo chiave nel modellare questa comunità di microrganismi.
- Gli Streptococchi mutans nella placca sono più abbondanti quando l’igiene orale è scarsa e il controllo glicemico è peggiore. E c’è una correlazione positiva tra la loro quantità e i livelli di HbA1c (l’emoglobina glicata, che ci dice come è andata la glicemia negli ultimi mesi).
- Gli Streptococchi mutans salivari, invece, non sembrano riflettere lo stato della carie, ma sono più influenzati dal controllo glicemico.
- La Candida albicans, sia salivare che della placca, è più presente quando la carie è più severa, indipendentemente dalla glicemia. La Candida albicans salivare ha mostrato una correlazione positiva con il punteggio CAST (cioè con la gravità della carie).
- I Lattobacilli salivari sembrano i migliori “spioni” per capire lo stato della carie, a prescindere dalla glicemia. Anche i Lattobacilli della placca hanno mostrato una correlazione positiva con il punteggio CAST.
Questi risultati, per quanto mi riguarda, sottolineano l’importanza di un approccio multidisciplinare nella gestione dei bambini con diabete di tipo 1. Non basta solo controllare la glicemia; è fondamentale anche monitorare la salute orale e, perché no, il carico microbico. Un buon controllo metabolico, esami dentistici regolari e un’attenzione costante all’igiene orale possono davvero fare la differenza nel prevenire o ritardare complicazioni legate al diabete, anche quelle che iniziano, silenziose, nella bocca dei nostri piccoli. Certo, ci sono tanti altri fattori in gioco – dalla dieta all’esposizione al fluoro, dalla genetica alla composizione della saliva – e questo studio ha delle limitazioni, come il non averli potuti valutare tutti. Ma è un passo avanti per capire meglio questo intricato rapporto e, spero, per migliorare la qualità di vita dei bambini.
Fonte: Springer







